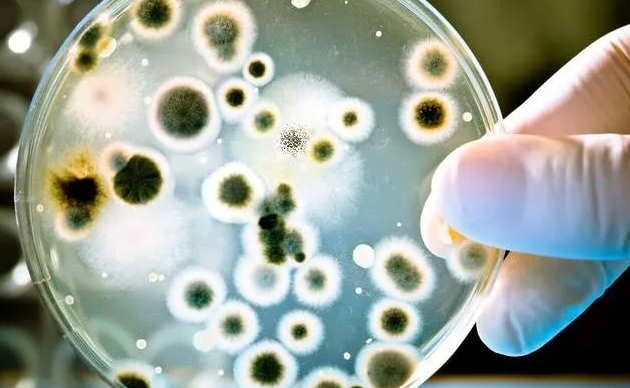

gaoshengkeji@163.com

在無菌生產工藝中,為了對無菌生產區域環境和微生物進行一個有效的控制,需要選擇合適的消毒方式,空間消毒的方式有紫外線照射,甲醛、環氧乙烷等氣體進行熏蒸。但是常規的消毒滅菌方法有諸多的缺點,如紫外線照射法,紫外燈的照射強度會隨使用時間的延長而衰減,什么時候達不到消毒要求我們不得面知,紫外線穿透率較弱,并且有死角,環境濕度對消毒效果影響較大,采用熏蒸,消毒周期長,空調系統需要長時間運行,能耗增加并且還存在二次污染的問題。臭氧消毒方式與上文消毒方式相比有以下優點,臭氧消毒以空氣或水為原料,不需要其它成分引入,并且消毒擴散均勻,不存在消毒死角,消毒快速。臭氧消毒后會分解成氧氣,所以臭氧消毒也稱之為綠色消毒。省去了消毒后的二次清潔。
潔凈區臭氧消毒是利用HVAC系統的循環風作為臭氧的載體,將臭氧發生器生產的臭氧由HVAC系統中的風機產生的壓力風源,擴散至整個潔凈區域,并使空氣中的臭氧濃度均勻分布,即可達到滅菌的目的。
臭氧對空氣中的微生物有明顯的殺滅作用,采用20mg/m3濃度的臭氧,作用30min,對自然菌的殺滅率達到90%以上。用臭氧消毒空氣,必須是在封閉空間,且室內無人條件下進行,消毒后至少經過30min才能進入,保證臭氧已經全部被降解,或濃度已降至不會對人員產生傷害的程度。這種消毒方式可用于手術室,病房,工廠潔凈生產車間等場所的空氣消毒。臭氧對物品表面上污染的微生物有殺滅作用,用臭氧氣體進行表面消毒,但作用緩慢,一般要求60mg/m3,相對濕度≥70%,作用60min~120min才能達到消毒效果。(摘自《消毒技術規范》)。
在潔凈區臭氧消毒效果的驗證前提是應先確認和校準的臭氧發生器技術指標是否滿足消毒的要求,主要指標的有臭氧產量、臭氧濃度和時間定時器等。并通過最終檢查細菌數、環境微生物水平、消毒時的濃度來確定消毒效果。
臭氧發生器的選擇,根據潔凈室的體積和HVAC系統的風管體積(或風量)、臭氧殺菌效率選用相應的臭氧發生器。可將發生器主機置于空調系統的總送風管或回風管道的合適位置,電源控制系設置于機房內。消毒時關閉相應的新風進口和回風排放閥門,使整個被消毒的潔凈區空氣通過凈化系統風管形成內循環。
臭氧消毒代替民前采用化學試劑熏蒸對物體表面、墻壁、地面及設備表面的消毒,其優點是在被消毒的房間里不需增加任何消毒設備,即可達到規范標準的要求,保持良好的工作環境,也可直接安裝在空氣處理設備中,使臭氧發生器的安裝與維護變得更為簡單和方便。
臭氧發生器消毒的計算,在設計臭氧消毒程序時,常依托于空調系統的運行將臭氧送入潔凈室內部,考慮臭氧濃度時,應針對消毒空間體積、空調系統總送風量、空調系統新風量、空調系統排風(含滲透風、泄漏風等)等參數綜合計算,然后選擇合適的臭氧發生器,并進行安裝調試、確認之后投入使用。
經驗公式
以選擇合適的臭氧發生器為前提,假設潔凈室(區)體積為V1,HVAC系統風管容積為V2,
保持潔凈區正壓所補充的新風的臭氧消耗量為V3,V3的確定根據消毒實踐。
則消毒空間體積為:V=V1+V2+V3
依據分式我們可歸納出較為可靠的經驗公式如下:
V=HVAC系統循環總風量(m3/h)×25%(假定新風補充量為25%)×10%(保持潔凈區
正壓需補充的新風量)×37.75%(計算應用臭氧半衰率的預算值)
即:V≈循環系統總風量×0.944%
臭氧濃度的確認選取以下房間作為擬測試消毒濃度的房間:凈化空調潔凈送風最遠端的房間、換氣次數最低的房間、關鍵工藝房間等。消毒過程中,使用便攜式臭氧濃度檢測儀對以上房間進行臭氧濃度的監測。消毒過程中,各房間臭氧濃度應符合消毒操作規程中規定的臭氧消毒濃度。考慮到臭氧對人體健康方面的副作用,推薦安裝在線臭氧濃度檢測儀,對消毒狀況進行監測。此情況下,可直接通過在線臭氧濃度監測儀獲取相關參數。生物指示劑挑戰性試驗在對目標區域執行臭氧消毒前,可將含菌量為1*103cfu/片的枯草芽孢桿菌生物指示劑放置于空白培養皿(或其他合適的承載容器)內,將培養皿置于被測試臭氧濃度的房間內,打開培養皿蓋子,使生物指示劑完全暴露在環境中,以便于臭氧消毒過程中能夠作用到生物指示劑上。在臭氧消毒結束后,回收生物指示劑,按照生物指示劑的培養要求進行培養。
培養結朿后對目標生物指示劑進行活菌培養計數,如每個測試點的殺滅對數值均>3.00,判定為臭氧消毒合格。臭氧殘留的確認臭氧消毒結束,通過指定時間新風置換后,潔凈室內的臭氧濃度不得高于0.1ppm(約0.20mg/m3)。
行業內也有的做法是,在消毒全過程,實施臭氧濃度檢測,當室內空氣濃度達到要求了,開始計時保持60min,消毒結束,進行空氣置換后,進行環境微生物的檢測,就是對潔凈區的沉降菌、浮游菌檢測,檢測結果應符合相應潔凈級別對環境微生物水平的要求。這算是一種間接證明環境已經符合要求的手段。
考慮到人員安全,在臭氧消毒時應注保證人員全部撤離消毒區域,控制出入口,采取張貼消毒標志等適當的方式進行的控制。應制定相應的應急預案,假如發生人員傷害事件,按應急預案處理。